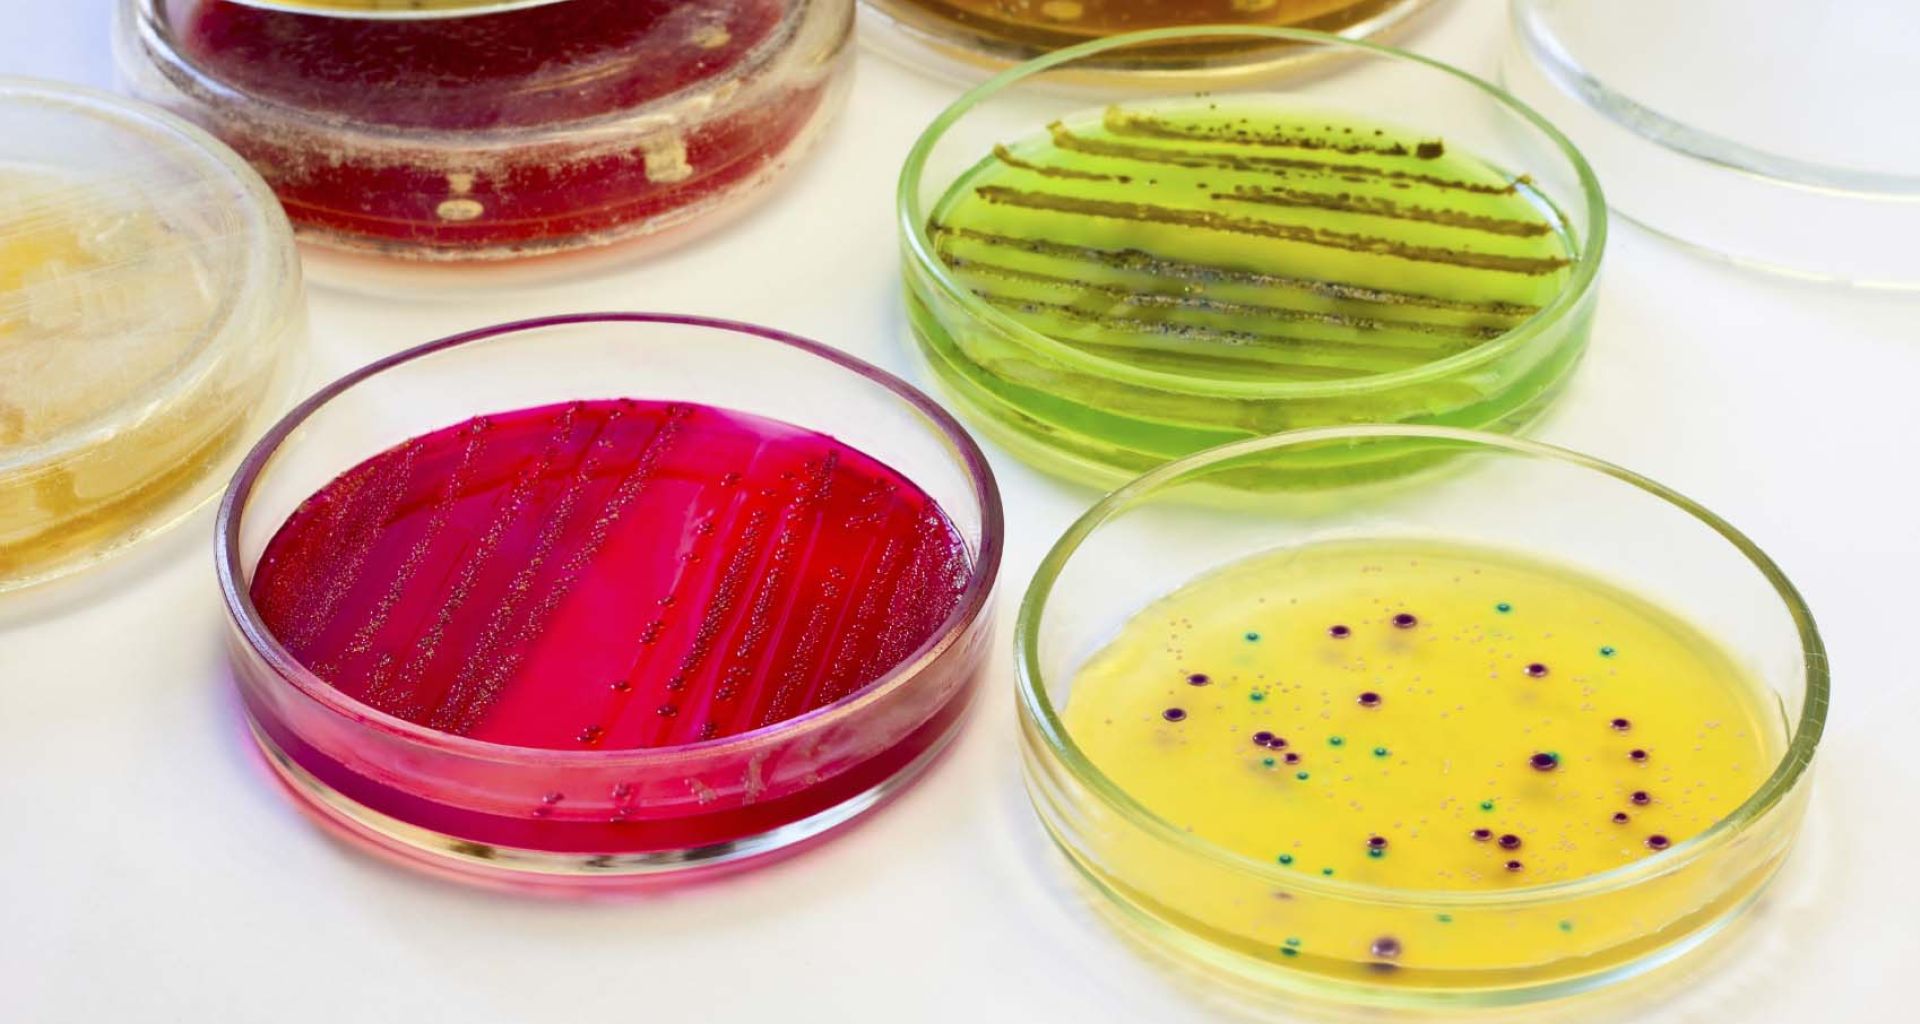
الميكروبات الممرضة والمخلفات الطبية 1 الميكروبات الممرضة والمخلفات الطبية

الميكروبات الممرضة والمخلفات الطبية
الإنسان والحيوان على احتكاك مباشر ويومي مع الميكروبات من عدة مصادر في البيئة المحيطة، فالميكروبات موجودة في التربة التي يمشون عليها والمياه التي يشربونها والغذاء الذي يتغذون عليه وحتى أجسادهم بها العديد من الميكروبات كساكن طبيعي، ولكن هنالك على كل حال عدد بسيط من الميكروبات والتي تعتبر ضارة ومسببة للأمراض. المخلفات الطبية ومنها المخلفات المعدية […]
الإنسان والحيوان على احتكاك مباشر ويومي مع الميكروبات من عدة مصادر في البيئة المحيطة، فالميكروبات موجودة في التربة التي يمشون عليها والمياه التي يشربونها والغذاء الذي يتغذون عليه وحتى أجسادهم بها العديد من الميكروبات كساكن طبيعي، ولكن هنالك على كل حال عدد بسيط من الميكروبات والتي تعتبر ضارة ومسببة للأمراض.
المخلفات الطبية ومنها المخلفات المعدية (Infectious waste) قد تحتوي على عدد كبير ومتنوع من الميكروبات الممرضة، وكل الأشخاص المعرضين للمخلفات الطبية عرضه للإصابة مثل الممرضات وأخصائيين المعامل وعمال النظافة وعمال نقل المخلفات وعمال المكبات وغيرهم، وهنالك عدة طرق لدخول الميكروبات لجسم الإنسان منها عند حدوث جرح أو قطع وخدش للجلد ببعض المخلفات الحادة الملوثة الإبر والمشارط، أو يمكن أن يدخل الميكروب عبر الأغشية المخاطية أو بواسطة التنفس أو البلع.
الجدول التالي يبين أمثلة للأمراض التي قد تنتقل بواسطة التعرض للمخلفات الطبية وسوائل الجسم الناقلة لتلك الأمراض (1).
| وسائل النقل | الميكروب المسبب | أنواع الأمراض |
| البراز والقيء | البكتيريا المعوية مثل السلمونيلا والكوليرا وبعض الطفيليات | الالتهابات المعوية |
| اللعاب والبصاق | السل الرئوي وفيروسات الحصبة وبكتيريا الالتهاب الرئوي | أمراض بالجهاز التنفسي |
| إفرازات العين | فيروس الهربس | أمراض العيون |
| إفرازات الجهاز التناسلي | بكتيريا السيلان وفيروسات الهربس | أمراض تناسلية |
| الصديد | البكتيريا الكروية (السبحية) | الالتهابات الجلدية |
| إفرازات الجلد | البكتيريا العصوية للجمرة الخبيثة | الجمرة الخبيثة |
| سائل الحبل الشوكي | بكتيريا الالتهاب السحايا | التهاب السحايا |
| الدم وإفرازات الجهاز التناسلي | فيروس الإيدز | الإيدز |
| الدم ومشتقاته كالأمصال | فيروسات الدم مثل الابيولا والمربورغ | حمى نزف الدم |
| الدم | بكتيريا الكروية (العنقودية) | تعفن الدم |
| الدم | بعض البكتيريا العصوية المعوية والبكتيريا الكروية | بكتيريا بالدم |
| الدم | خميرة الكنديدا اللبيكنس | فطريات بالدم |
| البراز | فيروس تليف الكبد الألفي | تليف الكبد الألفي |
| الدم وسوائل الجسم | فيروس تليف الكبد البائي والجيمي | تليف الكبد البائي والجيمي |
العديد من الميكروبات الموجودة بالمخلفات الطبية يمكن أن ينتج عنها عدوى بسبب التعرض لها، ولكن أكثر أنواع العدوى والأتي إثارة ضجة هي الإصابة بفيروسات الدم مثل فيروس الإيدز وفيروسات تليف الكبد البائي والجيمي وذلك راجع لوجود عدد كبير من الإصابات في العاملين بالصحة نتجت عن حوادث جرح ووخز بمخلفات طبية حادة. إعادة استخدام الإبر الغير معقمة متوقع أن يكون السبب في إصابة 8-16 مليون شخص بفيروسات الكبد البائية (HBV) و 2.3 – 4.7 مليون إصابة بفيروسات الكبد الجيمي (HCV) وحوالي 80 ألف إلى 160 إلف إصابة بفيروس الإيدز، ومعظم هذه الحالات كان من الممكن تفاديها إذا ما تما التعامل مع المخلفات الطبية بشكل جيد وسليم من إجراءات فرز وجمع ونقل والتخلص (2).
من ضمن أخطار المخلفات الطبية احتمال وجود بكتيريا مقاومة للعديد من المضادات الحيوية (Antibiotic Resistance Bacteria) وهذه الأنواع ظهرت بسبب العناية بالمريض في المستشفى من استعمال الأدوية والمطهرات وغيرها. بالإضافة لتلك الأخطار توجد كميات كبيرة ومركزة من الميكروبات الممرضة في بعض أنواع المخلفات مثل أطباق المزارع البكتيرية بمعامل التحاليل الطبية. وهذا يعني أن كمية الجرعة المناسبة من الميكروب الممرض والتي تسبب المرض (minimal infective dose) متوفرة بالمخلفات الطبية.
تعتبر المخلفات الطبية مخزن للميكروبات الممرضة ويمكن أن تسبب في تلوث ينتج عنها عدوى بمرض خطير، وفي حالة سوء التعامل مع المخلفات قد تنتقل تلك الميكروبات الممرضة بواسطة الاتصال المباشر أو عن طريق نواقل مرئية مثل الحشرات والقطط والكلاب أو نواقل غير مرئية مثل الهواء.
وتعتبر المخلفات الطبية بطريقة أو أخرى المسئولة عن العدوى البكتيرية المكتسبة بالمستشفيات (Nosocomial Infections) وهي إصابة المريض بمرض ميكروبي بعد دخوله للمستشفى بسبب مرض أخر.
عدت تقارير نوهت بمسئولية المخلفات الطبية في التسبب بأمراض نتيجة احتوائها على ميكروبات ممرضة، كالتقرير بخصوص إصابة ثلاث عاملين بمحطة معالجة المخلفات الطبية بالولايات المتحدة بميكروب السل (Mycrobacterium tuberculosis) نتيجة عملية تقطيع المخلفات قبل عمليات التخلص مما سبب في انتشار عصيات السل في الهواء وعدم وجود كممات التنفس وإهمال العاملين ساهم في ذلك. والتقرير الروسي عن إصابة أطفال بمرض الجدري نتيجة لعبثهم في سلة قمامة المستشفى ولعبهم بعبوات فارغة من التطعيمات (2).
دراسة أمريكية (3) أجريت على أربع محطات معالجة للمخلفات الطبية وجدت بقع دم متناثرة في 64% من مساحة العمل بتلك المحطات(By detection of hemoglobin)، 22% في نظارات الوقاية الشخصية للعاملين وفي 8% من ملابس العاملين، وأن أكثر الأشخاص عرضه لإصابات بميكروبات الدم هم العاملين بنقل المخلفات الطبية الغير المعالجة، وأن الاحتمالات تشير إلى أنه يمكن إصابة عامل إلى أربعة عاملين من إجمالي 10000 عامل بفيروس الإيدز. ودراسة أخرى أثبتت أن تناثر الدم كان سبب في انتقال فيروسات تليف الكبد الجيمي (4).
عمال جمع ونقل المخلفات بالإضافة لعمال مكبات القمامة أكثر عرضه للإصابة بميكروبات نتيجة تعاملهم مع المخلفات الصلبة بالمقارنة مع أفراد المجتمع الأخريين (4-5) ففي بعض الدول المتقدمة مثلاُ:
- الدنمارك، العمال أكثر عرضة للإصابة بالأمراض المعدية بنسبة 6 مرات.
- الدنمارك، العمال أكثر عرضة للإصابة بالأمراض الحساسية للشعب الهوائية بنسبة 2.6 مرة.
- سويسرا، العمال أكثر عرضه للإصابة بالالتهابات الرئوية المزمنة بنسبة 2.5 مرة.
- ايطاليا، العمال أكثر عرضه للإصابة بتليف الكبد بنسبة 1.5 مرة.
- الهند، دراسة 400 عامل أثبتت إصابة 71% بالالتهابات الرئوية بالمقارنة بنسبة 34% من المجموعة المقارنة (7).
- الفلبين، 23% من الأطفال المشتغلين في المكبات توجد لديهم مشاكل تنفسية وسعال
- مزمن وحوالي 19% لديهم ضيق في التنفس بالمقارنة مع الأطفال الأخريين (8).
- وأخيراً، أفضل طرق تفادي الإصابة بالميكروبات والجراثيم من المخلفات الطبية هو عدم التعرض لها من البداية، ولكن إذا كان من ضمن الوظيفة التعامل مع المخلفات الطبية فيجب أن يكون التعامل سليم وحذر، وأتباع الطرق السليمة والآمنة لجمع ونقل وتخزين والتخلص من المخلفات الطبية.
References:
- Pruss A, Giroult E, Rushbrook P. (1999). Safe management of wastes from health-care activities. Geneva, World Health Organization.
- Kennedy. M.E. (2001). Review of Health Impacts from Microbiological Hazards in Health-Care Wastes. World Health Organization Geneva.
- Leese KE, Cole EC, Jensen PA. (1999). Assessment of blood-splash exposures of medical-waste treatment workers. Enviro Hlth. January/February, 8-11.
- Satori M, Gaglietta M, LaTerra G, Manzin A, Navino C, Verzetti G. (1993) Transmission of hepatitis C via blood splash into conjunctiva. Scan J Inf Dis. 25:270-271.
- Poulsen OM, Breum NO, Ebbehoj N, Hansen AM, Ivens UI, van Lelieveld D, Malmros P Matthiasen L, Nielsen BH, Nielsen EM et al. Collection of domestic waste. Review of occupational health problems and their possible causes. (1995). Science of the Total Environment, , 170(1-2):1-19.
- Kanitz S, Franco Y, Roveta M, Patroone V, Raffo E. (1991). Sanitary landfilling: Occupational and health hazards. Proceedings of Sardinia 91, Third International Landfill Symposium, October.
- Nath KJ et al. Socio-economic and health aspects of recycling of urban solid wastes through scavenging. All India Institute of Hygiene and Public Health, Calcutta.
- Torres EB, Subida RD, Rabuco LB. (1991). The profile of child scavengers in Smokey Mountain, Balut, Tondo. University of Philippines College of Public Health, Manila,. pp 1-83and annexes.
اترك تعليقاً